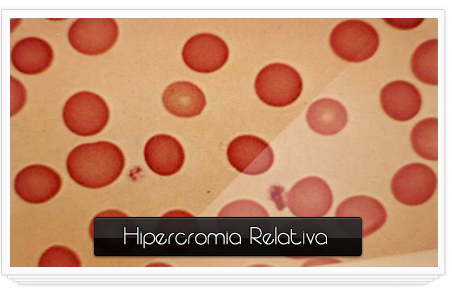

HCG
gonadotropina coriónica humana
La gonadotropina coriónica humana, gonadotrofina coriónica humana,o hCG es una hormona glicoproteica producida durante el embarazo por el embrión en desarrollo después de la fecundación y posteriormente por el sincitiotrofoblasto. La hCG también es producida en la hipófisis de los hombres y mujeres de todas las edades.
Durante la fase folicular de la mujer, las pequeñas cantidades de esta hormona, segregadas por la hipófisis, colaboran en la maduración de los óvulos.
En los hombres, también encontramos pequeñas cantidades de esta hormona, la cual estimula a su vez la producción de testosterona (hormona sexual masculina) en los testículos.
La función fundamental de la hCG es ejercida durante el embarazo: Esta hormona, segregada por el embrión en desarrollo poco después de la concepción, se encarga de mantener un cuerpo lúteo nutrido, capaz de seguir produciendo grandes cantidades de progesterona, fundamental para el desarrollo fetal.
Se cree que la hCG también beneficia la tolerancia inmunológica del embarazo: A través de ésta el cuerpo de la mujer no rechaza el feto durante el primer trimestre.
La HCG empieza a aumentar su producción una vez que se lleva acabo la fecundación llegando a su puno máximo en el primer trimestre , en la semana doce .
Esta hormona no puede ser detectada en el suero a partir de la doceava día del embarazo y se puede detectar en orina después del día 30.
ENFERMEDADES Y SUS CAUSAS
La enfermedad trofoblástica gestacional es conocida desde la antigüedad.
Trastornos placentarios, principalmente por fecundación defectuosa. La mola hidatídica es una degeneración hidrópica de las vellosidades coriónicas, que está limitada a la cavidad uterina, conservando, en la mayoría de los casos, la estructura de la vellosidad.
Hay una degeneración de la placenta con edema y quistificación de las vellosidades, formando hidátides, por lo que toma la apariencia de un gran racimo de uvas.
Mola hidatídica completa, es más frecuente y toda la placenta degenera a tejido molar, es anembrionada con material genético paterno solamente.
Tumores malignos del trofoblasto:
Mola invasiva (antiguamente llamado corioadenoma destruens), invade la cavidad uterina y/o estructuras vecinas pero continúa conservando la estructura de la vellosidad.
Coriocarcinoma, hay un crecimiento invasivo en el que no se reconoce la estructura vellositaria.5 En el 50% de los casos en los que aparece un coriocarcinoma, la mujer había sufrido una mola.
Tumor trofoblástico del lecho placentario, es una forma poco común (poco más de 200 casos reportados en la literatura) que puede ocupar endometrio y miometrio. Aparece en el miometrio y endometrio, lugar donde estuvo inserto el lecho placentario.
En los hombres, el aumento de los niveles de hCG está asociado con el cáncer de los testículos. Como lo reporta la Sociedad del Cáncer de los Estados Unidos, dependiendo del tipo de célula cancerosa, puede haber una secreción alta de hCG. Por ello, el análisis de la sangre es un componente esencial en el diagnóstico del cáncer de testículos al que se combina con otros estudios.Para los hombres que se están reponiendo de un cáncer testicular, los chequeos periódicos del hCG pueden ser un componente preventivo que deberás discutir con tu médico también.